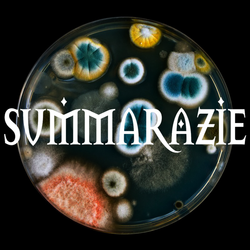
BACTERIZIE

SUMMARAZIE SUMMARAZIE
- Apr 28, 2022
- 1 min
RON
RON BIRTHPLACE : SHIGA BIRTHYEAR : 2000 INSTAGRAM : @SBOIRONAHH
70 view